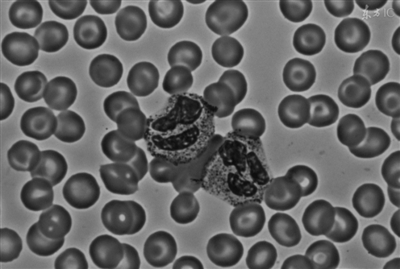

|
我们每个人的身体里确实都有癌细胞。但这句话又该怎么科学的解释一下呢?难道人人都会得癌症?癌细胞是怎么被咱给激发出来的?怎样才能不把它们招出来?”
正确理解“癌细胞人人有”
中国医学科学院肿瘤医院内科副主任主任医师马飞说,理论上每个人的体内,确实都有癌细胞的存在。啥叫癌细胞呢?别看咱总听这个词儿,但普通大众还真不见得清楚癌细胞到底是什么东东。
我们身体有上亿个细胞,它们都参与了身体的新陈代谢,每天除了会代谢掉旧的细胞,还会繁殖出新细胞。在细胞繁殖更替的过程当中,那些出了错的细胞就叫癌细胞。
别激动!人家偶尔出个错也是正常的,因为人体有上亿个细胞,细胞基数这么大,在分裂和繁殖的过程中,总归会有出错的机会。
但在人体强大的免疫功能监视下,多数情况下是会把它们都消灭掉的,或者把这个出错的细胞给纠正了。所以少量的错误细胞,是不太可能演变成癌症的。
错误细胞如何演变成癌?
马飞医生说,正常的细胞在更新换代之后就会凋亡。因为正常细胞它的生长和繁殖,是受调控的。
但如果是出错的细胞,又没有办法被人体排除掉,它就是一个“侵略者”,不仅不会死掉,还会变本加厉的在体内繁殖生长,直至有一天演变成了癌症。所以医学上,也把癌细胞叫做永生细胞。
虽然这种概率并不大,但正如我们前面所说,细胞每天都是在分裂的,每天都有可能出现错误细胞,因为有强大的免疫功能保护,大部分都会被免疫系统杀死。
但为什么有的出错细胞,却没有被人体排除掉呢?因为错误细胞“智商”更高一些,它会通过分泌出一些物质,来改变周边免疫系统的环境,从而抑制免疫系统。然后再伪装成正常细胞,不让免疫系统识别出自己的身份。
这种逃过免疫系统监视的现象,在医学上叫做“免疫逃逸”。一旦有发生免疫逃逸的癌细胞,它就会存活下来不停的繁殖,直至癌症的发生。
马飞医生说,在临床当中,通过影像学的检查手段,一公分的肿瘤就可以被发现了。而一公分的肿瘤,在体内大概就已经有10的9次方这么多的癌细胞了。
10的9次方这个概念,可能大家觉得太抽象,您只要记住人体的细胞数量巨大,如果体内的癌细胞,在10 的5次方以下,一般可以通过人体的免疫功能压制住。
如果体内癌细胞数量大于10的6次方,人体的免疫功能就可能压制不住它了。如果是到10的12次方,人就已经病入膏肓了。
凤凰网2016.12.26


 下一版
下一版




